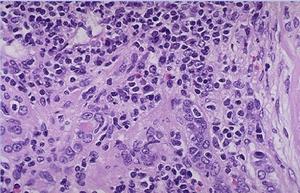
兒童腎盂腎炎

概述
兒童腎盂腎炎是由細菌感染所致的腎盂及腎實質的感染,有急性腎盂腎炎和慢性腎盂腎炎兩種。急性腎盂腎炎如治療不徹底,遷延不愈或反覆發作可轉為慢性腎盂腎炎。
症狀
(1) 急性腎盂腎炎 :①起病多較急 ,多有寒顫 、 高熱 、 面色蒼白等中毒症狀,可有噁心 、 嘔吐 、 腹瀉 、 食慾減退 等消化道症狀,甚至可有昏迷 、驚厥等神經系統症狀及腦膜刺激征,有的病例可有 發熱 或 低熱 。②較大的病兒常有尿頻 、 尿急 、 尿痛 及腎區痛或叩擊痛,有的可見肉眼血尿或膿尿 。
(2) 慢性腎盂腎炎 :①可為急性反覆感染所致,病程可遷延數月甚至數年。②病程長的可致生長發育遲緩,可出現間歇性發熱 、膿尿及細菌尿,並可出現慢性腎功能衰竭的表現。
病因
兒童腎盂腎炎
兒童腎盂腎炎感染途徑:
(1)上行感染 :即由尿道口經尿路或尿道周圍淋巴管上行感染 ,常見於女性嬰兒,致病菌多為大腸桿菌。
(2)血性感染 :上呼吸道感染 ,皮膚 膿皰瘡 ,敗血症等疾病,細菌經血液系統感染 ,致病菌多為鏈球菌或金黃色葡萄球菌。
(3)通過腸及腎臟之間的淋巴管蔓延而致。
診斷
從症體體進行診斷。
治療
一般治療急性期應臥床休息,予以充足水分,使之多排尿,並給足量維生素C及維生素B。
藥物治療(1)在選用有效的藥物治療之前,一般宜先作尿細菌培養及藥物敏感試驗。為有效控制復發及根治感染,採用至少兩月及至數月或一年以上的抗菌藥物治療。在臨床症狀明顯好轉或停藥後,連續兩次(兩次間歇為1~2月)尿的細菌培養轉為陰性,才可認為暫時控制了病原。以後定期隨訪,複查尿液,以免感染繼續潛伏。
(2)常用藥物:
①呋喃坦丁(呋喃妥因)5~10mg/kg/日,分3~4次口吸取,嚴重腎功能減退者慎用。
②磺胺類藥:磺胺異惡唑0.1~0.2g/kg/日,分4次口服,首劑加倍,磺胺甲基異惡唑50mg/kg頓服,以後按50mg/kg/日,每日服一次,首劑加倍(慢性腎盂腎炎有腎功能損害者,不用磺胺類藥)。
③烏洛托品:對其他藥物無效者,可選用,劑量0.3~0.9/次,日服3~4次。
④盂德立胺:遷延頑固者,可試用,劑量0.05g/kg/日,分3次口服,首劑加倍。
(1)有高熱、不安或因尿急、尿頻影響病兒睡眠時,可予以退熱、鎮靜藥物。(2)急性發作有排尿因難時可予鹼性藥物如枸椽酸鈉或碳酸氫鈉口服。
中藥治療與祖國醫學中濕熱淋相似,以清利濕熱為主。常用八正散配合導赤散加減。處方:杷子6g,黃柏9g,生地9g,木通3g,車前子9g,六一散9g,白茅根15g,可隨證加其它藥物:血尿重者加匾蓄9g,瞿麥9g,大小薊9g。熱重者加黃芩9g,寒水石9g。尿痛甚加元胡9g,甘草9g,青皮6g。尿混濁重如米湯汁者加石葦6g,旱蓮草15g。慢性腎盂腎炎在祖國醫學中屬虛寒淋,治以調補脾腎,通淋利濕。常用參苓術草湯配合金匱腎氣丸加減。處方:黃苓15g,黨參15g,茯苓15g,白朮9g,續斷9g,菟絲子9g,木通3g。隨症選加藥味,可加服金匱腎氣丸,每次半至一丸,1~2次/日。
藥物
維生素C ; 維生素B ;呋喃坦丁; 磺胺異惡唑 ;磺胺甲基異惡唑; 烏洛托品 ;枸椽酸鈉; 碳酸氫鈉 ;杷子; 黃柏 ;生地; 木通 ; 車前子 ; 六一散 ; 白茅根 ;匾蓄; 瞿麥 ;大 小薊 ; 黃芩 ;寒水石; 元胡 ; 甘草 ; 青皮 ;石葦;旱蓮草;黃苓; 黨參 ; 茯苓 ; 白朮 ; 續斷 ; 菟絲子 ; 木通 ...
易發人群
在小兒泌尿系感染中較常見。
